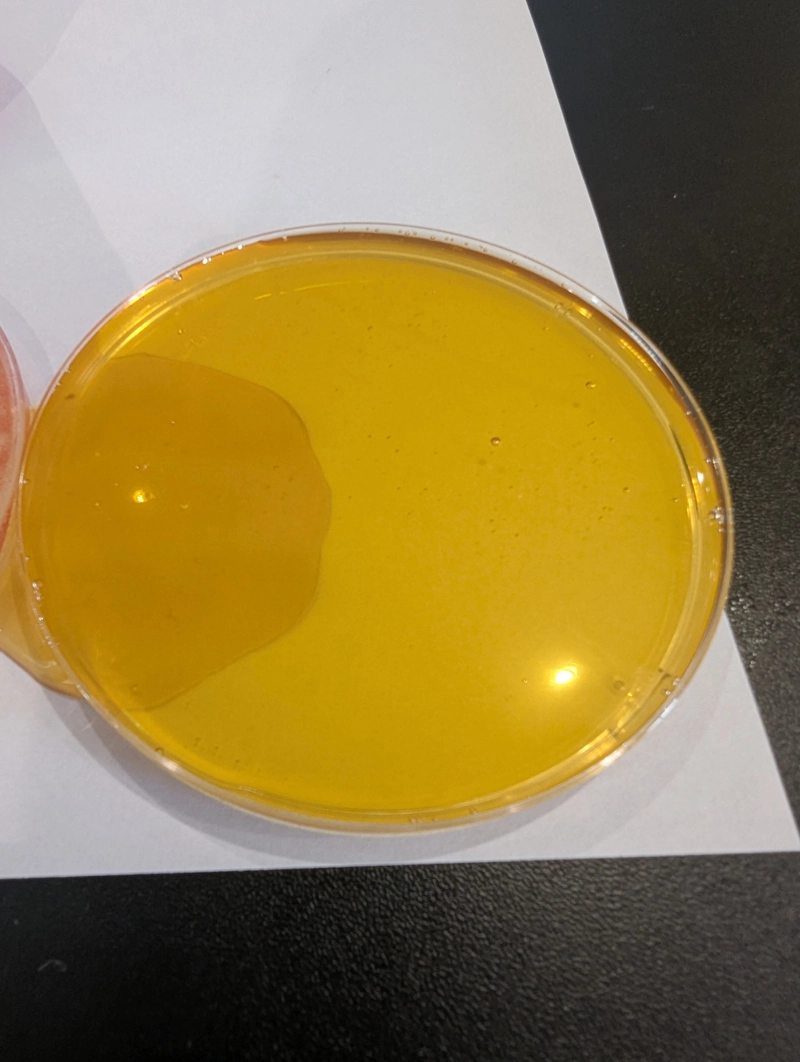

Aceite De Girasol Sin Refinar A Granel

Precio del producto
Precio a consultar
Información de pago y envío
Aceite De Girasol Sin Refinar A Granel
Sonyah
Detalles del producto
El aceite sin refinar se purifica mecánicamente, tiene un color amarillo oscuro y retiene los fosfolípidos, el caroteno, las vitaminas A, E y F (ácidos grasos insaturados linolénicos y linolénicos que no se sintetizan en el cuerpo, la necesidad de ellos es mayor para los humanos que para otras vitaminas). Clásicamente, este producto se usa para preparar platos fríos y ensaladas. El aceite de girasol se considera un producto rico en calorías, por lo que se consume en pequeñas cantidades. El aceite de girasol sin refinar es el más saludable y debe consumirse crudo.
Sobre el proveedor
Visita la página del proveedorContactar con el proveedor
Más productos del proveedor
Producto similar

Azúcar natural en ...
Azúcares naturales hechos de jugo de caña de azúcar, ...
Jaad Agro Private...

Azúcar natural en ...
El azúcar moreno en polvo es un edulcorante natural r...
Jaad Agro Private...

Aceite de palma pa...
El aceite de palma para cocinar de Yaapee Royal Foods...
Yaapee Royal Ente...

Suministro a grane...
La leche de coco en polvo es un producto seco y fluid...
viet delta indust...

Ñames frescos de c...
Dorry Tasty Foods ofrece ñame fresco, batatas y aceit...
Dorry tasty foods...

Vinagre de sidra d...
El jugo de manzana y el agua se utilizan para cre...
Natures Shopy

ACEITE DE LECHE DE...
El aceite de coco virgen, que se elabora con leche de...
Nonhalal product
Concentrado de jug...
El jugo concentrado de sandía ultrafiltrado es un pro...
26 Group

Concentrado natura...
Frozen Watermelon NFC es un concentrado natural conge...
26 Group

Concentrado de zum...
Concentrado de zumo de piña. 60 bx. Embalaje de bid...
26 Group


